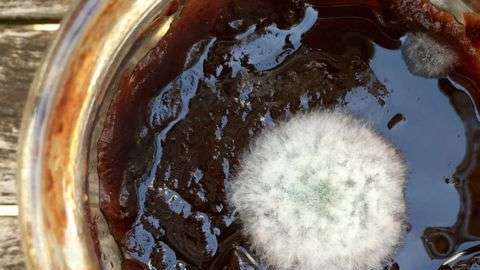
Los mohos pueden producir micotoxinas. A veces retirar la parte visible con una cuchara no es suficiente.

¿Qué alimentos puedes comer y cuáles no cuando les sale moho?
¿Qué tan seguro es retirar la superficie enmohecida en la comida y comer el resto?
Los mohos pueden producir micotoxinas. A veces retirar la parte visible con una cuchara no es suficiente. Crédito: MAERZKIND | Getty Images
¿Lo tiro o me lo como? Seguro que te has preguntado esto alguna vez al reabrir un bote medio olvidado de salsa de tomate o de mermelada y encontrarte una pelusilla grisacea sobre la superficie.
Los mohos son hongos microscópicos que se alimentan de materia animal o vegetal. Carnes, quesos, frutas, vegetales y panes sucumben a su invasión.
Lo que ves, de color verde, azul, blanco, gris o marrón son solo las esporas de esas decenas de miles de hongos diferentes. Por debajo hay tallos y raíces, que crecen en el alimento.
Entonces ¿es seguro retirar el moho y comer lo que queda? Depende. Algunos tipos de moho son más peligrosos que otros.
Sorprendentemente, el servicio de Seguridad alimentaria e Inspecciones (FSIS) del departamento de Agricultura de Estados Unidos, tiene información y recomendaciones detalladas sobre qué hacer y qué no hacer al encontrar moho en los alimentos.
Como dientes de león
Los hongos tienen ramas, tallos y raíces, que son como pequeños hilos.
“Las raíces pueden ser difíciles de ver cuando el moho crece en la comida y pueden profundizarse en el alimento”, informa FSIS.
Si un alimento tiene mucho moho en la superficie, las raíces lo habrán penetrado profundamente, advierten.
Algunos mohos pueden causar reacciones alérgicas y problemas respiratorios.
Otros, en las condiciones adecuadas pueden generar micotoxinas, que son sustancias venenosas para nuestra salud.
¿Cuales son los más peligrosos y cuales son inofensivos?
Las micotoxinas son producidas sobre todo por mohos que crecen en los granos y las nueves, aunque también pueden estar presentes en otros productos como el apio, el jugo de uva y las manzanas.
De hecho la presencia potencial de estas toxinas es de gran importancia para la industria de los cereales, semillas, nueces y frutos deshidratados, según las condiciones de almacenamiento.
Las micotoxinas más peligrosas son las llamadas aflatoxinas, que son cancerosas.
Son producidas por hongos del género Aspergillus, que crecen sobre todo en el cacahuete o maní, pero también se pueden encontrar en nueces de Brasil y almendras.
Por otro lado la patulina, otro tipo de mitocoxina, también se puede encontrar con frecuencia en manzanas y jugos de manzana no fermentados.
En términos muy generales, como una regla sin matices, se podría decir que los mohos verdes y blancos tienden a ser inofensivos, mientras que los marrones deberían ser evitados.
Pero hay excepciones: algunos mohos verdes o blancos sí pueden producir toxinas y no se puede pueden identificar o distinguir a simple vista.
Por ejemplo, los mohos que se utilizan para la fabricación de quesos son seguros. Muchos son variedades de la vieja conocida Penicilina.
Sin embargo eso no quiere decir que todas las Penicilinas sean seguras.
¿Qué alimentos con moho se pueden salvar y cuales es mejor descartar?
FSIS recomienda descartar la comida enmohecida que tiene un alto contenido húmedo, porque puede estar contaminada por debajo de la superficie.
También advierte que algunos alimentos enmohecidos pueden contener bacterias que crecen con el moho.
Entre los alimentos que recomiendan descartar están los fiambres, tocino, salchichas, carnes cocinadas, pasta, granos cocinados, yogures, mermeladas y crema ácida.
Como excepción menciona algunos salamis y carnes curadas duras, que suelen tener cierto moho en la superficie que es seguro raspar antes de consumir.
La página de FSIS puntualiza que es difícil que el moho penetre en los alimentos densos, no porosos.
El moho en las frutas y vegetales duros, con bajo contenido húmedo, como el repollo, los pimientos o las zanahorias, se puede retirar para consumir el resto del alimento. Recomiendan cortar al menos 2cm y medio alrededor y por debajo del moho.
En el caso de los quesos duros, también es seguro retirar la parte enmohecida y consumir el resto.
Sin embargo, en el caso de los quesos blandos (cottage, queso crema) y los ya rayados, recomiendan tirarlo.
Por otro lado FSIS recomienda descartar los quesos que ya se hacen con moho, como el roquefort, azul, brie y camembert, si desarrollan mohos que no son parte del proceso de fabricación, porque pueden ser peligrosos.
Ahora puedes recibir notificaciones de BBC Mundo. Descarga la nueva versión de nuestra app y actívalas para no perderte nuestro mejor contenido.




